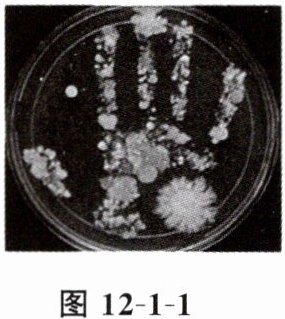

2. 下列有关细菌的叙述中,错误的是(
A.细菌的生殖方式是分裂生殖
B.细菌的遗传物质存在于细胞核中
C.细菌很小,肉眼观察不到其形态结构
D.细菌有球形、杆形和螺旋形三种基本形态
B
)。A.细菌的生殖方式是分裂生殖
B.细菌的遗传物质存在于细胞核中
C.细菌很小,肉眼观察不到其形态结构
D.细菌有球形、杆形和螺旋形三种基本形态
答案:
2.B 解析:细菌是原核生物,没有成形的细胞核。
3. 细菌分布很广,种类繁多,下列选项不属于细菌的是(
A.金黄色葡萄球菌
B.大肠杆菌
C.幽门螺杆菌
D.酵母菌
D
)。A.金黄色葡萄球菌
B.大肠杆菌
C.幽门螺杆菌
D.酵母菌
答案:
3.D 解析:金黄色葡萄球菌、大肠杆菌、幽门螺杆菌均属于细菌,酵母菌属于真菌。
4. 假设小红的手上此刻有100个细菌,细菌的繁殖速度按每30分钟繁殖一代计算,理想状态下,3小时后小红手上的细菌数目是(
A.3200个
B.12800个
C.6400个
D.25600个
C
)。A.3200个
B.12800个
C.6400个
D.25600个
答案:
4.C
5. 下列不是所有微生物在培养过程中都必需的条件是(
A.充足的氧气
B.适宜的温度
C.一定的水分
D.营养物质
A
)。A.充足的氧气
B.适宜的温度
C.一定的水分
D.营养物质
答案:
5.A
6. 人的手上有大量微生物,无菌固体培养基经人手按压,培养一段时间后呈现图12-1-1所示的结果。下列相关叙述错误的是(
[]
A.培养基上生长的菌落形态、大小不同
B.手上的微生物不一定都对人体有害
C.手上可能既有细菌又有真菌
D.用清水洗手可起到灭菌作用
D
)。[]
A.培养基上生长的菌落形态、大小不同
B.手上的微生物不一定都对人体有害
C.手上可能既有细菌又有真菌
D.用清水洗手可起到灭菌作用
答案:
6.D 解析:清水可以洗掉部分细菌和真菌,但不能杀死细菌和真菌。
1. 微生物培养的一般步骤是(
①配制培养基 ②高温灭菌 ③冷却后接种 ④恒温培养
A.①②③④
B.②①③④
C.①④②③
D.②①④③
A
)。①配制培养基 ②高温灭菌 ③冷却后接种 ④恒温培养
A.①②③④
B.②①③④
C.①④②③
D.②①④③
答案:
1.A
2. 在一个研究光照对微生物菌落生长影响的对照实验中,以下哪一组设置符合单一变量原则?(
A.实验组:有光照,使用牛肉膏蛋白胨培养基;对照组:无光照,使用麦芽汁培养基
B.实验组:有光照,30℃培养;对照组:无光照,35℃培养
C.实验组:有光照,接种大肠杆菌;对照组:无光照,接种酵母菌
D.实验组:有光照,正常空气环境;对照组:无光照,正常空气环境,其他条件相同且适宜
D
)A.实验组:有光照,使用牛肉膏蛋白胨培养基;对照组:无光照,使用麦芽汁培养基
B.实验组:有光照,30℃培养;对照组:无光照,35℃培养
C.实验组:有光照,接种大肠杆菌;对照组:无光照,接种酵母菌
D.实验组:有光照,正常空气环境;对照组:无光照,正常空气环境,其他条件相同且适宜
答案:
2.D
3. 在探究某种抗生素对微生物生长影响的实验中,如果实验组的菌落数量远远少于对照组,以下哪个结论是合理的?(
A.这种抗生素对微生物的生长有促进作用
B.这种抗生素对微生物的生长没有影响
C.这种抗生素对微生物的生长有抑制作用
D.这种抗生素被微生物分解利用了
C
)A.这种抗生素对微生物的生长有促进作用
B.这种抗生素对微生物的生长没有影响
C.这种抗生素对微生物的生长有抑制作用
D.这种抗生素被微生物分解利用了
答案:
3.C
查看更多完整答案,请扫码查看